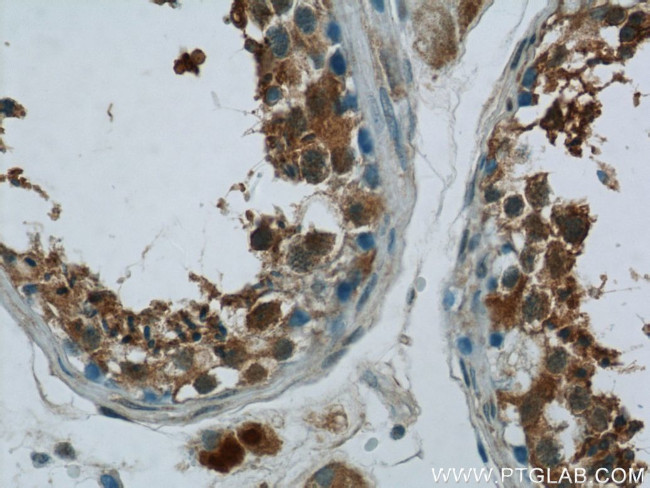
ZNF746 Antibody in Immunohistochemistry (Paraffin) (IHC (P))

Search
Proteintech
ZNF746 Polyclonal Antibody
{{$productOrderCtrl.translations['antibody.pdp.commerceCard.promotion.promotions']}}
{{$productOrderCtrl.translations['antibody.pdp.commerceCard.promotion.viewpromo']}}
{{$productOrderCtrl.translations['antibody.pdp.commerceCard.promotion.promocode']}}: {{promo.promoCode}} {{promo.promoTitle}} {{promo.promoDescription}}. {{$productOrderCtrl.translations['antibody.pdp.commerceCard.promotion.learnmore']}}
产品信息
24543-1-AP
种属反应
已发表种属
宿主/亚型
分类
类型
抗原
偶联物
形式
浓度
规格
纯化类型
保存液
内含物
保存条件
运输条件
产品详细信息
The calculated molecular weight of ZNF746 is 69 kDa, but phosphorylated ZNF746 is about 80-85 kDa.
Immunogen sequence: MQIKQEGEL QLQEQQALGV EAWAAGQPDI GEEPWGLSQL DSGAGDISTD ATSGVHSNFS TTIPPTSWQT DLPPHHPSSA CSDGTLKLNT AASTEDVKIV IKTEVQEEEV VATPVHPTDL EAHGTLFGPG QATRFFPSPA QEGAWESQGS SFPSQDPVLG LREPARPERD MGELSPAVAQ EETPPGDWLF GGVRWGWNFR CKPPVGLNPR TGPEGLPYSS PDNGEAILDP SQAPRPFNEP CKYPGRTKGF GHKPGLKKHP AAPPGGRPFT CATCGKSFQL QVSLSAHQRS CGAPDGSGPG TGGGGSGSGG GGGGSGGGSA RDGSALRCGE CGRCFTRPAH LIRHRML (186-531 aa encoded by BC068505 )
靶标信息
ZNF746 is a transcription repressor that specifically binds to the 5'-TATTTT[T/G]-3' consensus sequence on promoters and represses transcription of PGC-1-alpha (PPARGC1A), thereby playing a role in regulation of neuron death.
仅用于科研。不用于诊断过程。未经明确授权不得转售。
生物信息学
蛋白别名: PARIS; Parkin-interacting substrate; parkin-interacting sustrate; unnamed protein product; Zinc finger protein 746
基因别名: 2810407L07Rik; AI317225; PARIS; RGD1306209; Zfp746; ZNF746
UniProt ID: (Human) Q6NUN9, (Mouse) Q3U133
Entrez Gene ID: (Human) 155061, (Mouse) 69228, (Rat) 312303